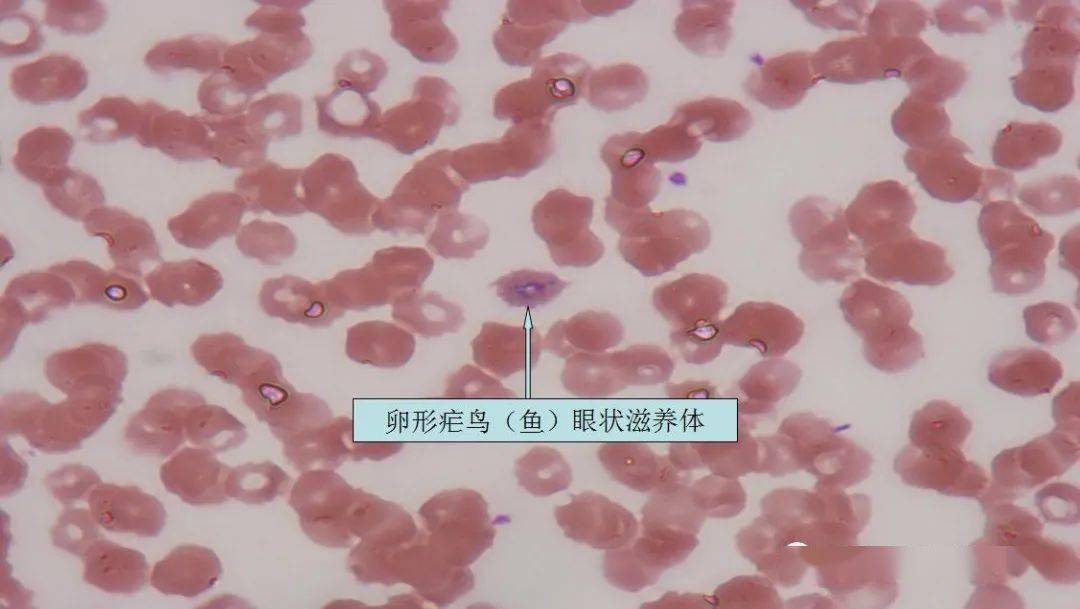
b3 例 p.f.3 例 p.o.疟原虫种类分类:9 例国人非洲归来.
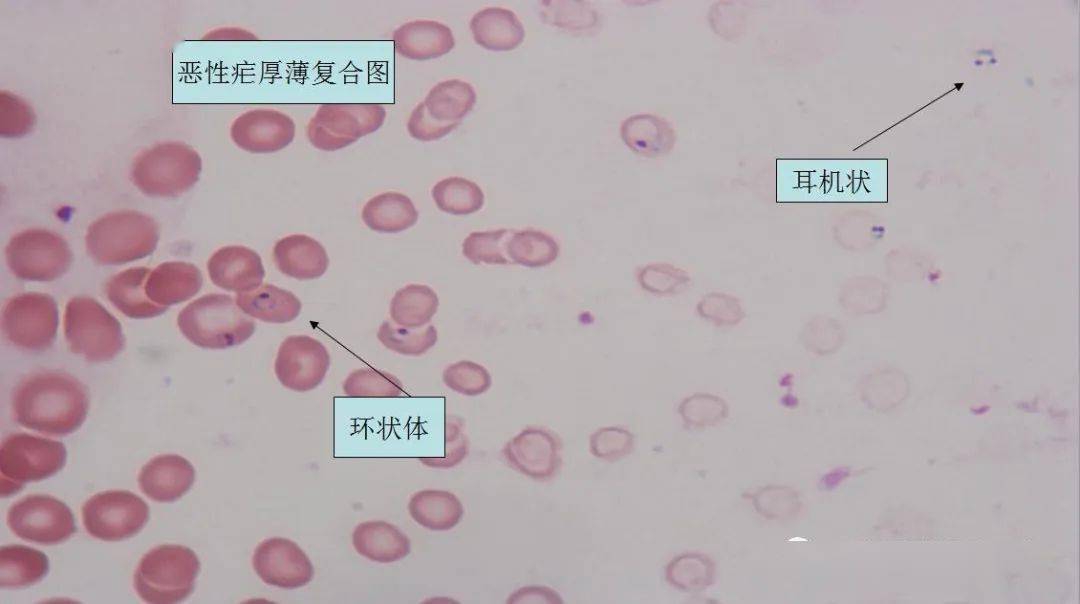
b3 例 p.f.3 例 p.o.疟原虫种类分类:9 例国人非洲归来.

三日疟原虫

三日疟原虫镜下形态
图片尺寸1620x2160
三日疟原虫镜下形态
图片尺寸1620x2160
三日疟原虫镜下形态
图片尺寸1080x810
三日疟检验案
图片尺寸1080x519
三日疟检验案
图片尺寸1080x504
三日疟原虫镜下形态
图片尺寸1620x2160
三日疟原虫镜下形态
图片尺寸1080x810
三日疟检验案
图片尺寸1080x508
三日疟原虫镜下形态
图片尺寸1080x810
三日疟检验案
图片尺寸1080x500
b3 例 p.f.3 例 p.o.疟原虫种类分类:9 例国人非洲归来.
图片尺寸1080x1347
三日疟检验案
图片尺寸1080x505
b3 例 p.f.3 例 p.o.疟原虫种类分类:9 例国人非洲归来.
图片尺寸1080x609
三日疟原虫镜下形态
图片尺寸1080x810
b3 例 p.f.3 例 p.o.疟原虫种类分类:9 例国人非洲归来.
图片尺寸1080x1288
b3 例 p.f.3 例 p.o.疟原虫种类分类:9 例国人非洲归来.
图片尺寸1080x611
(plasmodium vivax grassi & feletti,1890),三日疟原虫(plasmodium
图片尺寸751x450
恶性疟 间日疟 三日疟 卵形疟
图片尺寸1080x810
b3 例 p.f.3 例 p.o.疟原虫种类分类:9 例国人非洲归来.
图片尺寸1080x604
三日疟检验案
图片尺寸1080x514